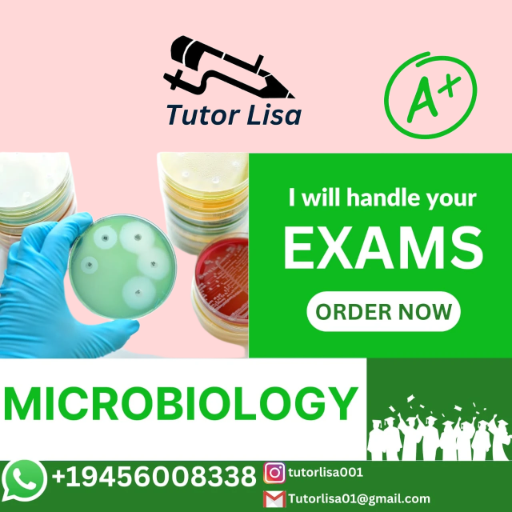
MICROBIOLOGY TUTORING

MICROBIOLOGY TUTORING
MICROBIOLOGY
$10.00
We provide customized online tutoring services! With extensive experience in medical education, we deliver clear, engaging, and personalized lessons to assist students in mastering intricate Microbiology concepts. Whether you are getting ready for exams or looking to enhance your understanding, our interactive virtual sessions offer flexible scheduling and thorough support.
Schedule your session with us now and begin excelling in Microbiology.
